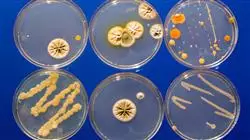

Universitäre Qualifikation
Die größte Fakultät für Ernährung der Welt"
Präsentation
Ein Universitätskurs, der zu einer Referenz für die Modulation der humanen Mikrobiota durch Probiotika und Präbiotika werden soll”
Es ist wichtig, die Arten von Lebensmitteln zu kennen, in denen beide Elemente vorhanden sind. Probiotika sind in Joghurt, fermentiertem Soja, Sauerkraut und Kefir enthalten. Andererseits wurden präbiotische Stoffe in Bananen, dunkler Schokolade, grünem Blattgemüse oder Vollkornprodukten nachgewiesen. Dies sind nur einige Beispiele für eine breite Palette von Lebensmitteln, die diese Eigenschaften aufweisen, was die enge Beziehung zwischen der humanen Mikrobiota und der Ernährung unterstreicht.
Hier kommt der Ernährungsberater ins Spiel, der sein umfassendes Wissen über die Eigenschaften von Lebensmitteln und die am besten geeigneten Nahrungsergänzungsmittel unter Beweis stellen muss. Aus diesem Grund werden Sie im Rahmen dieses TECH-Studiengangs in diesem Bereich weitergebildet, um Diäten zu entwickeln, die an die Bedürfnisse jedes einzelnen Patienten angepasst sind und individuelle und wirksame Lösungen für seine chronischen Krankheiten bieten.
In diesem Bereich werden die Studenten die nützlichen Bestandteile von Probiotika und Präbiotika und die vorhandenen Arten analysieren. Aber natürlich werden sie auch das Sicherheitsprofil dieser Elemente im Hinblick auf einen verantwortungsvollen Umgang mit ihnen eingehend untersuchen. Ein weiterer Höhepunkt des Programms wird ein umfassender Überblick über ihre klinischen Anwendungen in verschiedenen Bereichen sein.
Ernährungsberater haben die Möglichkeit, diesen Abschluss online zu erwerben, was ihnen mehr Flexibilität und Bequemlichkeit bietet. In dieser Reihe haben sie unbegrenzten Zugang zu interaktiven Diagrammen, Kurzanleitungen zum Vorgehen, realen Fallstudien oder Lehrvideos. Und das alles mit nur einem Internetanschluss.
Steigern Sie die Lebensqualität Ihrer Patienten, damit sie ihre chronischen Krankheiten besser bewältigen können, durch personalisierte Strategien, die auf dem Vorhandensein von probiotischen und präbiotischen Substanzen basieren”
Dieser Universitätskurs in Probiotika, Präbiotika, Mikrobiota und Gesundheit enthält das vollständigste und aktuellste wissenschaftliche Programm auf dem Markt. Die wichtigsten Merkmale sind:
- Die Entwicklung von Fallstudien, die von Experten für Probiotika und Präbiotika vorgestellt werden
- Die grafische, schematische und äußerst praktische Inhalte, mit denen er konzipiert ist liefert Ernährung und praktische Informationen zu den für die berufliche Praxis wesentlichen Disziplinen
- Praktische Übungen, bei denen der Selbstbewertungsprozess zur Verbesserung des Lernens genutzt werden kann
- Sein besonderer Schwerpunkt liegt auf innovativen Methoden
- Theoretische Vorträge, Fragen an den Experten, Diskussionsforen zu kontroversen Themen und individuelle Reflexionsarbeit
- Die Verfügbarkeit des Zugangs zu Inhalten von jedem festen oder tragbaren Gerät mit Internetanschluss
Der Wandel ist hier und jetzt. Verbessern Sie Ihr Wissen über Probiotika und Präbiotika und integrieren Sie sie mit den wirksamsten Strategien in die Gestaltung Ihrer Ernährungspläne”
Das Dozententeam des Programms besteht aus Experten des Sektors, die ihre Berufserfahrung in diese Fortbildung einbringen, sowie aus renommierten Fachleuten von führenden Unternehmen und angesehenen Universitäten.
Die multimedialen Inhalte, die mit der neuesten Bildungstechnologie entwickelt wurden, werden der Fachkraft ein situiertes und kontextbezogenes Lernen ermöglichen, d. h. eine simulierte Umgebung, die eine immersive Fortbildung bietet, die auf die Ausführung von realen Situationen ausgerichtet ist.
Das Konzept dieses Programms konzentriert sich auf problemorientiertes Lernen, bei dem die Fachkraft versuchen muss, die verschiedenen Situationen aus der beruflichen Praxis zu lösen, die während des gesamten Studiengangs gestellt werden. Zu diesem Zweck wird sie von einem innovativen interaktiven Videosystem unterstützt, das von renommierten Experten entwickelt wurde.
Schreiben Sie sich jetzt ein und bereiten Sie sich von zu Hause aus optimal vor, während Sie das Programm mit Ihrer beruflichen Tätigkeit kombinieren"

Verbessern Sie Ihre Entscheidungsfindung, indem Sie sich mit echten Fallstudien auseinandersetzen, in denen Sie die Bedingungen der einzelnen Patienten für eine Ernährungsintervention zum Ausgleich ihrer Mikrobiota genauer untersuchen müssen"
Warum bei TECH studieren?
TECH ist die größte digitale Universität der Welt. Mit einem beeindruckenden Katalog von über 14.000 Hochschulprogrammen, die in 11 Sprachen angeboten werden, ist sie mit einer Vermittlungsquote von 99% führend im Bereich der Beschäftigungsfähigkeit. Darüber hinaus verfügt sie über einen beeindruckenden Lehrkörper mit mehr als 6.000 Professoren von höchstem internationalem Prestige.

Studieren Sie an der größten digitalen Universität der Welt und sichern Sie sich Ihren beruflichen Erfolg. Die Zukunft beginnt bei TECH”
Die beste Online-Universität der Welt laut FORBES
Das renommierte, auf Wirtschaft und Finanzen spezialisierte Magazin Forbes hat TECH als „beste Online-Universität der Welt“ ausgezeichnet. Dies wurde kürzlich in einem Artikel in der digitalen Ausgabe des Magazins festgestellt, in dem die Erfolgsgeschichte dieser Einrichtung „dank ihres akademischen Angebots, der Auswahl ihrer Lehrkräfte und einer innovativen Lernmethode, die auf die Ausbildung der Fachkräfte der Zukunft abzielt“, hervorgehoben wird.
Eine disruptive Studienmethode, ein hochmoderner Lehrkörper und seine praktische Ausrichtung: der Schlüssel zum Erfolg der TECH.
Die umfassendsten Lehrpläne in der Universitätslandschaft
TECH bietet die vollständigsten Lehrpläne in der Universitätslandschaft an, mit Lehrplänen, die grundlegende Konzepte und gleichzeitig die wichtigsten wissenschaftlichen Fortschritte in ihren spezifischen wissenschaftlichen Bereichen abdecken. Darüber hinaus werden diese Programme ständig aktualisiert, um den Studenten die akademische Avantgarde und die gefragtesten beruflichen Kompetenzen zu garantieren. Auf diese Weise verschaffen die Abschlüsse der Universität ihren Absolventen einen bedeutenden Vorteil, um ihre Karriere erfolgreich voranzutreiben
TECH verfügt über die vollständigsten und intensivsten Lehrpläne im aktuellen Hochschulpanorama.
Die besten internationalen Top-Lehrkräfte
Der Lehrkörper der TECH besteht aus mehr als 6.000 Professoren von höchstem internationalen Ansehen. Professoren, Forscher und Führungskräfte multinationaler Unternehmen, darunter Isaiah Covington, Leistungstrainer der Boston Celtics, Magda Romanska, leitende Forscherin am Harvard MetaLAB, Ignacio Wistumba, Vorsitzender der Abteilung für translationale Molekularpathologie am MD Anderson Cancer Center, und D.W. Pine, Kreativdirektor des TIME Magazine, um nur einige zu nennen.
Zum Lehrkörper der TECH gehören Experten von internationalem Rang, die auf verschiedene Bereiche der Gesundheit, Technologie, Kommunikation und Wirtschaft spezialisiert sind.
Eine einzigartige Lernmethode
TECH ist die erste Universität, die Relearning in allen ihren Studiengängen einsetzt. Es handelt sich um die beste Online-Lernmethodik, die mit internationalen Qualitätszertifikaten renommierter Bildungseinrichtungen ausgezeichnet wurde. Darüber hinaus wird dieses disruptive akademische Modell durch die „Fallmethode“ ergänzt, wodurch eine einzigartige Online-Lehrstrategie entsteht. Es werden auch innovative Lehrmittel eingesetzt, darunter ausführliche Videos, Infografiken und interaktive Zusammenfassungen.
TECH kombiniert Relearning und die Fallmethode in allen ihren Hochschulprogrammen, um ein hervorragendes theoretisches und praktisches Studium zu gewährleisten, wann und wo immer Sie wollen.
Die größte digitale Universität der Welt
TECH ist die weltweit größte digitale Universität. Wir sind die größte Bildungseinrichtung mit dem besten und umfangreichsten digitalen Bildungskatalog, der zu 100% online ist und die meisten Wissensgebiete abdeckt. Wir bieten weltweit die größte Anzahl eigener Abschlüsse sowie offizieller Grund- und Aufbaustudiengänge an. Insgesamt sind wir mit mehr als 14.000 Hochschulabschlüssen in elf verschiedenen Sprachen die größte Bildungseinrichtung der Welt.
TECH verfügt über den umfangreichsten Katalog akademischer und offizieller Programme der Welt und bietet ihn in mehr als 11 Sprachen an.
Google Partner Premier
Der amerikanische Technologieriese hat TECH mit dem Logo Google Partner Premier ausgezeichnet. Diese Auszeichnung, die nur 3% der Unternehmen weltweit erhalten, unterstreicht die effiziente, flexible und angepasste Erfahrung, die diese Universität den Studenten bietet. Die Anerkennung bestätigt nicht nur die maximale Präzision, Leistung und Investition in die digitalen Infrastrukturen der TECH, sondern positioniert diese Universität auch als eines der modernsten Technologieunternehmen der Welt.
Google hat TECH durch die Verleihung des Logos Google Partner Premier in die Top 3% der weltweit führenden Technologieunternehmen aufgenommen.
Die offizielle Online-Universität der NBA
TECH ist die offizielle Online-Universität der NBA. Durch eine Vereinbarung mit der größten Basketball-Liga bietet sie ihren Studenten exklusive Universitätsprogramme sowie eine breite Palette von Bildungsressourcen, die sich auf das Geschäft der Liga und andere Bereiche der Sportindustrie konzentrieren. Jedes Programm hat einen einzigartig gestalteten Lehrplan und bietet außergewöhnliche Gastredner: Fachleute mit herausragendem Sporthintergrund, die ihr Fachwissen zu den wichtigsten Themen zur Verfügung stellen
TECH ist von der NBA, der weltweit führenden Basketball-Liga, als ihre offizielle Online-Universität anerkannt worden
Die von ihren Studenten am besten bewertete Universität
Die Studenten haben TECH auf den wichtigsten Bewertungsportalen als die am besten bewertete Universität der Welt eingestuft, mit einer Höchstbewertung von 4,9 von 5 Punkten, die aus mehr als 1.000 Bewertungen hervorgeht. Diese Ergebnisse festigen die Position der TECH als internationale Referenzuniversität und spiegeln die Exzellenz und die positiven Auswirkungen ihres Bildungsmodells wider
TECH ist die von ihren Studenten am besten bewertete Universität der Welt.
Führend in Beschäftigungsfähigkeit
TECH ist es gelungen, die führende Universität im Bereich der Beschäftigungsfähigkeit zu werden. 99% der Studenten finden innerhalb eines Jahres nach Abschluss eines Studiengangs der Universität einen Arbeitsplatz in dem von ihnen studierten Fachgebiet. Ähnlich viele erreichen einen unmittelbaren Karriereaufstieg. All dies ist einer Studienmethodik zu verdanken, die ihre Wirksamkeit auf den Erwerb praktischer Fähigkeiten stützt, die für die berufliche Entwicklung absolut notwendig sind.
99% der TECH-Absolventen finden innerhalb von knapp einem Jahr nach Abschluss ihres Studiums eine Anstellung.
Universitätskurs in Probiotika, Präbiotika, Mikrobiota und Gesundheit
Probiotika, Präbiotika, das Mikrobiom und die Gesundheit sind in einem faszinierenden und komplexen Gleichgewicht in unserem Körper eng miteinander verbunden. Diese Themen haben in den letzten Jahren im Bereich der Gesundheit und der wissenschaftlichen Forschung stark an Bedeutung gewonnen. Aus diesem Grund hat die TECH Technologische Universität den Universitätskurs in Probiotika, Präbiotika, Mikrobiom und Gesundheit entwickelt, der eine hervorragende Möglichkeit bietet, sich in diesem Bereich zu qualifizieren, ohne das Haus verlassen zu müssen. Dieses vollständig virtuelle Programm wird Ihren Lehrplan um die aktuellsten Kompetenzen auf dem Markt ergänzen, damit Sie in diesem Gesundheitsbereich effektiv arbeiten können. In diesem Kurs werden Sie sich eingehend mit der entscheidenden Rolle befassen, die Probiotika und Präbiotika bei der Aufrechterhaltung eines gesunden Mikrobioms spielen. Wenn Sie die Geheimnisse dieser Substanzen aufdecken, werden Sie verstehen, wie sie die Verdauung verbessern, das Immunsystem stärken und eine optimale Gesundheit fördern können.
Erwerben Sie Ihren Abschluss von der weltweit größten Online-Fakultät für Ernährung
Dieses Programm, das von den besten Spezialisten von TECH entwickelt wurde, wird Ihnen das Wissen vermitteln, das Sie brauchen, um die richtigen Probiotika zu identifizieren und auszuwählen, sei es durch fermentierte Lebensmittel oder Nahrungsergänzungsmittel, um ihre Vorteile zu maximieren. Sie werden auch in die Welt der Präbiotika eintauchen und erfahren, wie diese das Wachstum nützlicher Bakterien im Darm fördern und so ein optimales Umfeld für die Gesundheit der Verdauung schaffen. Schließlich werden Sie sich mit der Beziehung zwischen dem Mikrobiom und der allgemeinen Gesundheit befassen und untersuchen, wie Veränderungen in der bakteriellen Zusammensetzung mit chronischen Krankheiten und Stoffwechselstörungen zusammenhängen können. Auf diese Weise werden Sie sowohl Strategien zur Aufrechterhaltung eines gesunden mikrobiotischen Gleichgewichts als auch Möglichkeiten zur Integration gesunder Gewohnheiten in Ihren täglichen Lebensstil entdecken."







